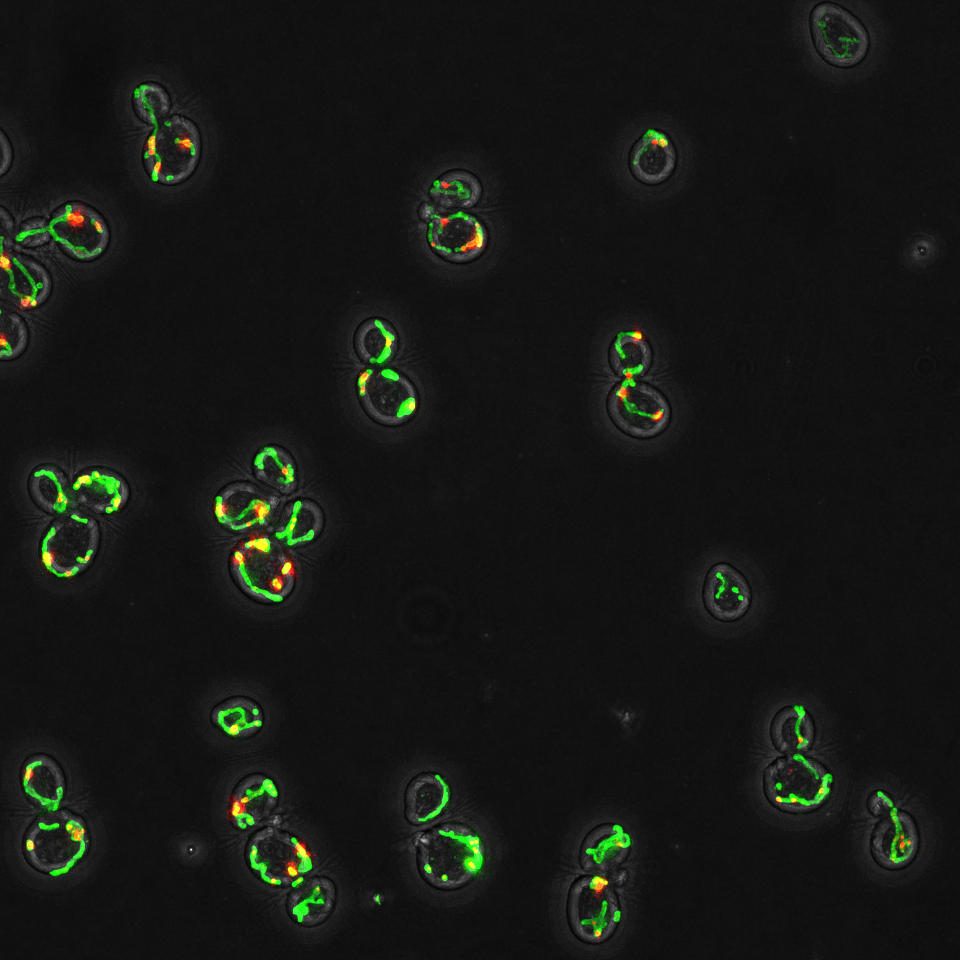
Products

Pipelines customized for your analyses
Our pipelines can be used individually or in tandem with each other.
Each pipeline is fully automated, optimized, and validated specifically for quantifying the topology and dynamics of mitochondrial networks in budding yeast. Each pipeline has also been tested across a range of imaging platforms (Zeiss Spinning disk, GE SIM OMX, LSM780, LSM770, LSM880) and fluorophores used to label mitochondria (BFP, EGFP, mCherry, mScarlet).
Yeast Cell Segmentation & Classification
Rapid automated identification, classification, and cartography of yeast cells…
Organelle Cellular Localization
Identifies organelle regional localization and migration within the yeast cell…
Mitochondrial Segmentation
Fast ML driven 3D volumetric segmentation of fluorescently labeled mitochondria…
Mitochondria Network Analysis
Runs common network analysis algorithms and structure-to-structure analysis on…
Mitochondria Dynamics Analysis
Analyze mitochondrial network dynamics over time (velocity, MSD) and structural…
Mitochondrial Content Analysis
Quantification of mitochondrial content (i.e. membrane potential dyes,…